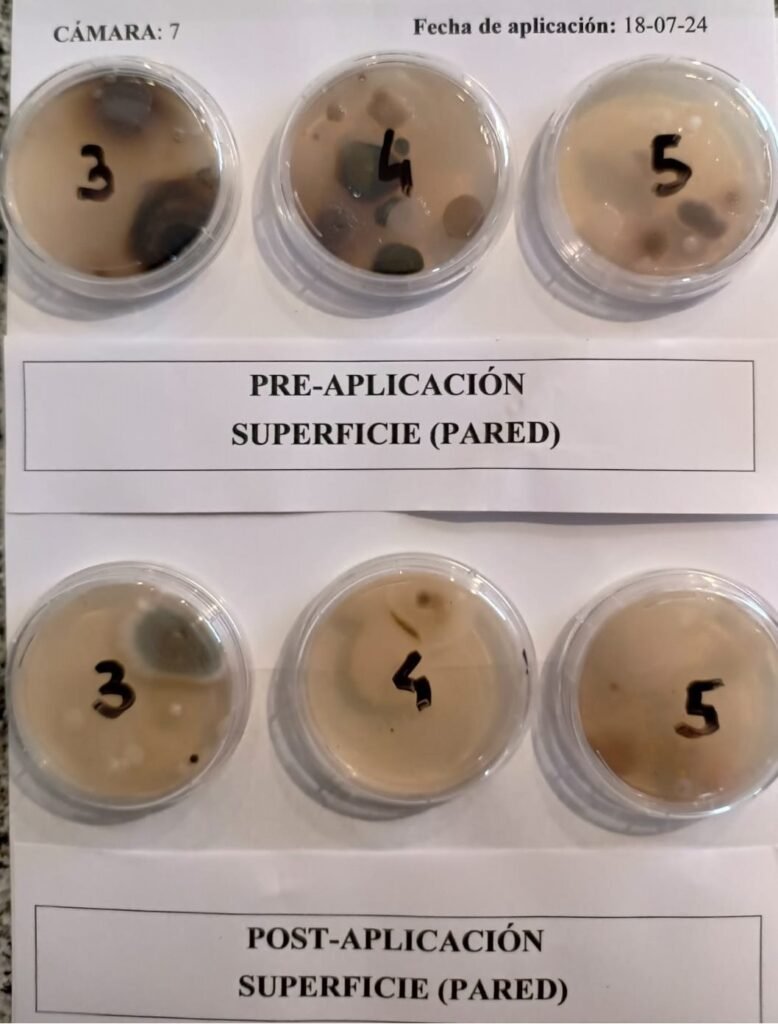

Servicios
Asesoramiento técnico
Ofrecemos un servicio integral de consultoría técnica para empresas y productores frutícolas que buscan optimizar su producción, mejorar la calidad de sus frutos y aumentar la rentabilidad de sus cultivos. Nuestro equipo realiza una evaluación completa del estado actual del sistema productivo (condiciones del suelo, sanidad vegetal, manejo agronómico y potencial productivo).
Diseñamos planes estratégicos adaptados a las condiciones agroclimáticas, la variedad frutal y los objetivos del productor. Esto incluye programación de labores, manejo del riego y técnicas de poda, floración y cosecha. Desarrollamos programas de nutrición basados en análisis de suelo, agua y tejido vegetal.

Ensayos a campo, microparcelas y laboratorio
Diseñamos y ejecutamos ensayos de productos pre-comerciales bajo condiciones reales de producción, evaluando su eficacia, fitotoxicidad y efecto sobre el rendimiento y la calidad de los cultivos.
Realizamos pruebas comparativas de insecticidas, acaricidas, fungicidas, fertilizantes, bioestimulantes y protectores solares, aplicando protocolos rigurosos y análisis estadísticos confiables, lo que garantiza resultados objetivos y transferibles al campo.


División fitopatología
Realizamos ensayos a campo e in vitro para evaluar la eficacia de fungicidas y biofungicidas en el control de enfermedades agrícolas. Estos estudios determinan su desempeño en condiciones reales y controladas, analizando su acción preventiva, curativa y su efecto sobre los patógenos.
En el laboratorio, en pruebas in vitro se estudia el comportamiento frente a hongos y pseudohongos, mientras los ensayos a campo validan su efectividad en distintas condiciones ambientales y estadios fenológicos de los cultivos.
Contamos con protocolos propios y adaptables, personal especializado y herramientas estadísticas que aseguran resultados precisos y reproducibles, fundamentales para el desarrollo, posicionamiento y registro de productos fitosanitarios.
Brindamos un servicio integral para la evaluación de patógenos de poscosecha en frutales a campo y poscosecha, en línea de empaque y cámara frigorífica, que incluye la identificación, cuantificación, identificación de puntos críticos de contaminación y diseño de estrategias de manejo. Para ello, se llevan a cabo visitas técnicas, recolección de muestras de fruta, superficies y ambientes, detección de cepas de hongos resistentes a fungicidas y elaboración de planes de trabajo adaptados a cada sistema productivo.


División Bioclimatología agrícola- BIOCLIMATICGROW
Ofrecemos soluciones adaptadas a las condiciones locales, integrando información proveniente de sensores meteorológicos, modelos bioclimáticos, pronósticos y estado de cultivos mediante herramientas de soporte a la decisión.
Análisis bioclimático personalizado para optimizar calidad y rendimiento según las condiciones microclimáticas de tu unidad productiva. Instalación y asesoramiento en sensores meteorológicos, incluyendo soporte para la adquisición de equipos. Mapas térmicos en campo y cámaras, para monitorear variabilidad y riesgos climáticos.
Estudios de factibilidad productiva, para identificar zonas con potencial agrícola y evaluar cultivos tradicionales y emergentes. Si ya contás con estación meteorológica propia, te ayudamos a traducir los datos en información clave para mejorar tus decisiones agronómicas.


Laboratorio de calidad
Realizamos análisis clave para evaluar madurez y calidad en frutos de pepita y carozo, esenciales en cosecha, poscosecha y comercialización.
📋 Parámetros Incluidos:
✔ Firmeza de pulpa
✔ Sólidos solubles totales (°Brix)
✔ Acidez titulable
✔ Índice de degradación de almidón
✔ Color de superficie
✔ Materia seca
✔ Test de cracking
✔ Análisis morfológico de frutos (peso, calibre y forma)
✔ Análisis de poder germinativo y viabilidad de semillas
✔ Pureza
✔ Peso de 1.000 semillas
✔ Test de vigor
Aplicamos metodologías estandarizadas que aseguran resultados precisos y comparables para una mejor toma de decisiones.


Madurez precosecha
Realizamos el seguimiento de la evolución de madurez de frutos, fundamental para determinar el momento óptimo de cosecha según el destino comercial.
Tomamos muestras directamente en chacra o recibimos las enviadas por el productor, y analizamos parámetros como firmeza, sólidos solubles, acidez, color e índice de almidón.
Esta información permite definir con precisión la ventana de cosecha, optimizando la calidad, conservación y rendimiento del producto. Un servicio clave para productores, empacadores y exportadores que buscan tomar decisiones basadas en datos objetivos.


Madurez poscosecha/cámaras frigoríficas
Ofrecemos el servicio de monitoreo de la evolución de madurez durante la poscosecha, con evaluaciones periódicas de fruta almacenada en cámaras frigoríficas o de atmósfera controlada.
Analizamos parámetros clave como firmeza, sólidos solubles, acidez, materia seca, color y desórdenes fisiológicos, con el objetivo de conocer el comportamiento del fruto en conservación, anticipar riesgos y tomar decisiones a tiempo en cuanto a manejo o destino comercial.
También evaluamos la eficacia de tecnologías como 1-MCP, ayudando a validar su efecto sobre la firmeza, retraso de maduración y prevención de desórdenes.
Monitoreo de limpieza y desinfección de líneas de empaque y cámaras
Nuestro servicio está diseñado para evaluar la efectividad del proceso de limpieza y desinfección en cámaras frigoríficas y líneas de empaque.

Venta de placas PDA
Ofrecemos placas descartables listas para usar, con medio de cultivo PDA (Papa Dextrosa Agar), para la detección de hongos y levaduras en ambientes.
📦 Presentaciones disponibles:
Placas PDA de 90 mm (ambiente)
Placas PDA tipo RODAC (superficies)
✨ Características:
Placas esterilizadas y descartables
Medio selectivo para hongos y levaduras
Listas para incubar y realizar recuento de colonias
Aptas para programas de control higiénico en industrias alimentarias, cámaras frigoríficas, plantas de empaque, laboratorios y más
📌 Consultanos por asesoramiento técnico para el diseño de planes de control sanitario.


Capacitaciones
Brindamos programas de formación teórico-prácticos dirigidos a personal técnico y operarios, orientados al control de calidad de frutos desde el campo hasta el empaque.
📝 Temas abordados:
Evaluación de calidad en precosecha
Control en báscula y líneas de empaque
Determinación de índices de madurez en laboratorio
Identificación de fisiopatías en frutas
Los cursos son presenciales o in company, incluyen práctica con muestras reales, materiales y certificado. Se adaptan a distintos cultivos y necesidades específicas de cada empresa.



